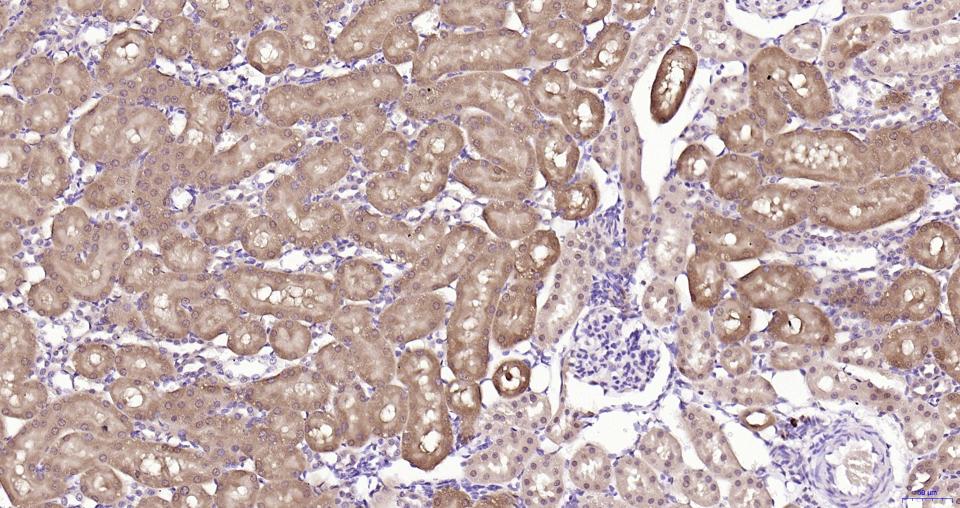
GPX4 Recombinant Rabbit mAb(bs
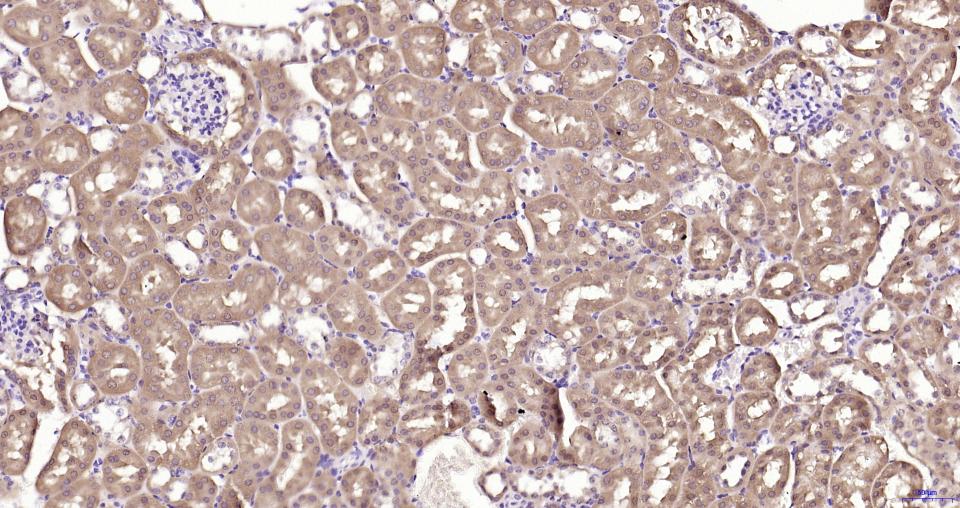
GPX4 Recombinant Rabbit mAb(bs

相关产品推荐更多 >

GABPA Rabbit pAb, PerCP-Cy5.5 conjugated(bs-13261R-PerCP-Cy5.5)-100ul
¥2980
ORAV1 Rabbit pAb, BF750 conjugated(bs-6559R-BF750)-100ul
¥2980
LC3A/B Rabbit pAb, Cy5.5 conjugated(bs-11731R-Cy5.5)-100ul
¥2980
Caspase-1 P10 Rabbit pAb, BF750 conjugated(bs-20617R-BF750)-100ul
¥2980
Bax Recombinant Rabbit mAb, PE conjugated(bsm-52316R-PE)-100ul
¥3200
万千商家帮你免费找货
0 人在求购买到急需产品
- 详细信息
- 文献和实验
- 技术资料
- 应用范围:
产品信息以Bioss网站为准
- 规格:
50ul/100ul/25ul
| 规格: | 50ul | 产品价格: | ¥1400.0 |
|---|---|---|---|
| 规格: | 100ul | 产品价格: | ¥2500.0 |
| 规格: | 25ul | 产品价格: | ¥800.0 |
| 产品编号 | bsm-61552R |
| 英文名称 | GPX4 Recombinant Rabbit mAb |
| 中文名称 | 谷胱甘肽过氧化酶4重组兔单抗 |
| 英文别名 | GPX4; GSHPx-4; MCSP; mitochondrial; PHGPx; phospholipid hydroperoxidase; snGPx; snPHGPx; Sperm nucleus glutathione peroxidase. |
| 产品应用 | WB=1:500-2000, IHC-P=1:50-200, IHC-F=1:50-200, ICC/IF=1:50-200, IF=1:50-200 Not yet tested in other applications. |
| 交叉反应 | Human, Mouse, Rat |
| 抗体来源 | Rabbit |
| 免疫原 | A synthesized peptide derived from human GPX4 |
| 亚型 | IgG |
| 性状 | Liquid |
| 纯化方法 | affinity purified by Protein A |
| 克隆类型 | Recombinant |
| 理论分子量 | 22 |
| 实际分子量 | 17 |
| 储存液 | 0.01M TBS (pH7.4) with 1% BSA, 0.02% Proclin300 and 50% Glycerol. |
| 研究领域 | Cancer > Cancer Metabolism > Cellular metabolic process Metabolism > Pathways and Processes > Mitochondrial Metabolism > Mitochondrial markers Metabolism > Pathways and Processes > Redox metabolism > Antioxidants Metabolism > Types of disease > Cancer Signal Transduction > Metabolism > Mitochondrial |
| 亚基 | Monomer. Has a tendency to form higher mass oligomers. |
| 亚细胞定位 | Isoform Mitochondrial: Mitochondrion. Isoform Cytoplasmic: Cytoplasm. |
| 组织特异性 | Present primarily in testis. |
| 相似性 | Belongs to the glutathione peroxidase family. |
| 功能 | Protects cells against membrane lipid peroxidation and cell death. Required for normal sperm development and male fertility. Could play a major role in protecting mammals from the toxicity of ingested lipid hydroperoxides. Essential for embryonic development. Protects from radiation and oxidative damage. |
| 保存条件 | Store at 4℃ for short term. Store at -20℃ for long term. Avoid repeated freeze/thaw cycles. |
| 注意事项 | This product as supplied is intended for research use only, not for use in human, therapeutic or diagnostic applications. |
| 背景资料 | Protects cells against membrane lipid peroxidation and cell death. Required for normal sperm development and male fertility. Could play a major role in protecting mammals from the toxicity of ingested lipid hydroperoxides. Essential for embryonic development. Protects from radiation and oxidative damage. |
| 应用 | 推荐稀释比例 |
| {WB} | {1:500-2000} |
| {IHC-P} | {1:50-200} |
| {IHC-F} | {1:50-200} |
| {ICC/IF} | {1:50-200} |
| {IF} | {1:50-200} |

风险提示:丁香通仅作为第三方平台,为商家信息发布提供平台空间。用户咨询产品时请注意保护个人信息及财产安全,合理判断,谨慎选购商品,商家和用户对交易行为负责。对于医疗器械类产品,请先查证核实企业经营资质和医疗器械产品注册证情况。
文献和实验[IF={{ 4.9 }}] {Bin Huang. et al. Sculpting Liver-Related Injury in Type 2 Diabetes Mellitus: Decoding Serum Ferritin's Correlation and Ferroptosis Pathways. J NUTR BIOCHEM. 2025 Jul;:110044} {IHC} {Mouse}
技术资料暂无技术资料 索取技术资料





